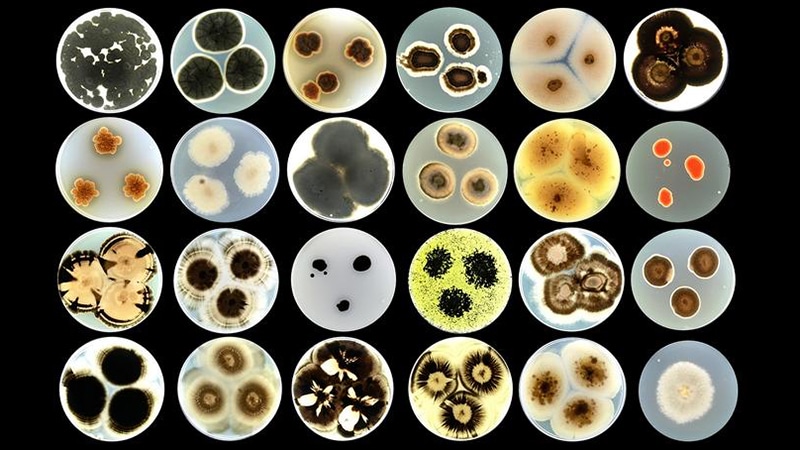

Tatuaggi viventi sugli edifici: così i muri respirano, si rigenerano e puliscono l’aria
Pareti che reagiscono al caldo, si riparano da sole e puliscono l’aria? Non è un’idea da fantascienza, ma una tecnologia in fase di sperimentazione concreta. Un gruppo di ricercatori europei, grazie al progetto REMEDY, sta trasformando le pareti degli edifici in superfici vive, usando inchiostri composti da microrganismi. L’obiettivo è chiaro: integrare la vita nei...
Pareti che reagiscono al caldo, si riparano da sole e puliscono l’aria? Non è un’idea da fantascienza, ma una tecnologia in fase di sperimentazione concreta. Un gruppo di ricercatori europei, grazie al progetto REMEDY, sta trasformando le pareti degli edifici in superfici vive, usando inchiostri composti da microrganismi. L’obiettivo è chiaro: integrare la vita nei materiali da costruzione, rendendo gli edifici parte attiva dell’ambiente.
In pratica, si tratta di veri e propri “tatuaggi viventi”, realizzati stampando su pareti e tetti una miscela di batteri, funghi e alghe. Questi organismi vivono sulla superficie degli edifici, dove possono assorbire CO₂, segnalare eventuali danni strutturali, resistere agli agenti patogeni e – in alcuni casi – perfino emettere luce.
Ogni anno, milioni di metri quadrati di nuove facciate e tetti vengono costruiti o ristrutturati. Solo nell’Unione Europea, nei prossimi 25 anni, parliamo di oltre 9,4 miliardi di metri quadrati. Se anche solo una parte di queste superfici venisse convertita in aree bioattive, il potenziale sarebbe enorme.
Lo sostiene Tom Ellis, professore all’Imperial College di Londra, tra i coordinatori del progetto:
Abbiamo a disposizione tantissima
LaCittaNews è un motore di ricerca di informazione in formato magazine, aggrega e rende fruibili, tramite le sue tecnologie di ricerca, in maniera automatica, gli articoli più interessanti presenti in Rete. LaCittaNews non si avvale di nessuna redazione editoriale. => DISCLAIMER



